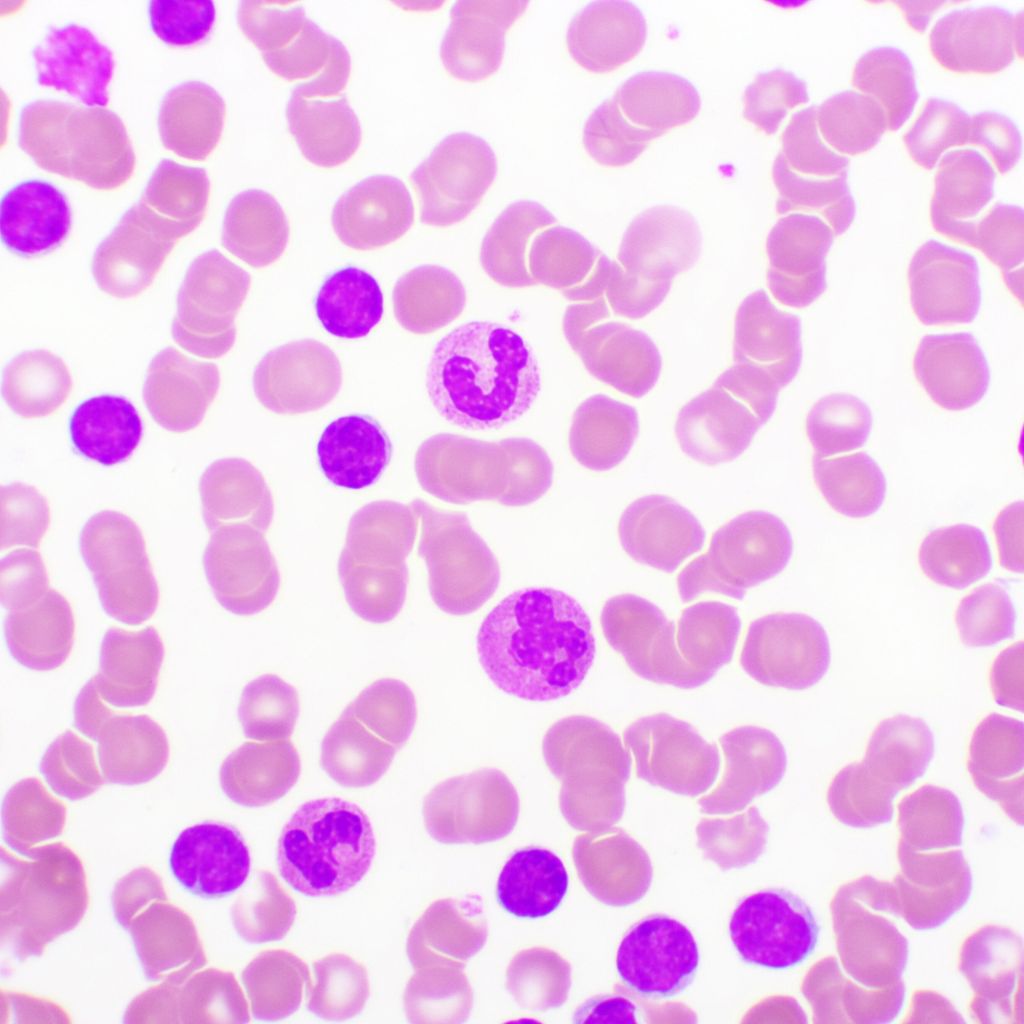
6JahresDaten aus ELEVATETN sprechen für 1L Acalabrutinib

Aclarubicin (INN) or aclacinomycin A is an anthracycline drug that is used in the treatment of cancer in China. It was previously approved for use in Europe but was discontinued in 2004 due to being rarely prescribed and unprofitable.
However, it has subsequently been reevaluated due to possible advantages over other chemotherapeutic drugs in the treatment of certain cancers such as acute myeloid leukemia.
Soil bacteria Streptomyces galilaeus can produce aclarubicin.
It can induce histone eviction from chromatin upon intercalation.
References